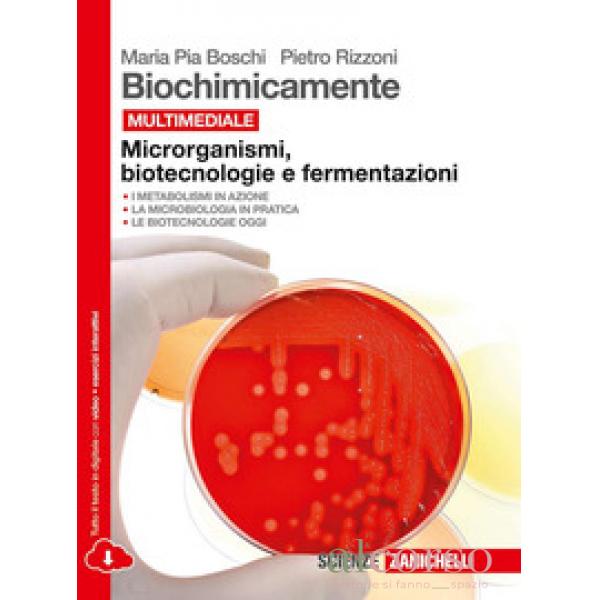

STUDIAMO LA CHIMICA. ESSENZIALE. PER LE SCUOLE...
Prezzo
16,00 €
Non disponibile